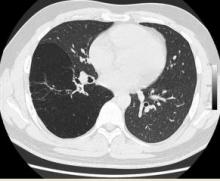

Uniportal Video-Assisted Thoracoscopic Lobectomy of a Congenital Cystic Adenomatoid Malformation and Broncho-Vascular Atresia [1]
Background
Congenital cystic adenomatoid malformation (CCAM) of the lung is a rare congenital malformation.This anomaly has been rarely described in adults when in association with bronchial and vascular atresia. There are few reports in the literature describing thoracoscopic lobectomy in patients with this unusual anomaly. This video is the first report of a lung resection of a CCAM via a single-port thoracoscopy.
Methods
A 35-year-old male was admitted to our department for surgery having been diagnosed with CCAM and bronchial atresia. A CT scan showed a cystic lesion in the right lower lobe according to CCAM (Figure 1). Bronchoscopy revealed absence of segment 6 bronchus. He had been suffering from recurrent pneumonias since childhood. Due to persistent symptoms he was offered lung resection by video-assisted thoracoscopic surgery (VATS). The entire lower lobe was transformed into a huge cyst, so a right lower lobectomy was performed through a single 4 cm incision with no rib spreading.
Figure 1. CT scan showing a huge cystic lower lobe.
Results
The total surgical time was 60 minutes. The patient was discharged home on the second postoperative day without complications after the drain was removed. The final pathological examination revealed CCAM.
Conclusions
Video-assisted thoracoscopic lobectomy is a safe and effective option for treatment of symptomatic CCAM. The presence of anatomical anomalies and recurrent pneumonia increases the difficulty of surgery but does not contraindicate the thoracoscopic approach. The uniportal thoracoscopic surgery is feasible in these patients in experienced thoracoscopic centers.
Surgical Technique
The patient was placed in a left lateral decubitus position. A VATS approach through a single 4 cm incision was made in the left 5th intercostal space with no rib spreading (Figure 2A). The camera was placed in the posterior part of the incision working with the instruments below camera (Figure 2B). The entire lower lobe was transformed into a huge cyst. The lobe was detached from adhesions by using energy devices (bipolar and ultrasound technology). The inferior pulmonary vein was exposed, dissected, and stapled. The anterior and posterior part of the fissure was divided by using a stapler. We confirmed the absence of the pulmonary artery branch for the apical segment of the lower lobe. The basal artery was exposed in the fissure, dissected by using a right angle clamp, and divided with a stapler. The final step was to divide the basal lower lobe bronchus.The specimen was inserted in a protective bag and removed without rib spreading.The remainder of the lung was inflated and a single intercostal drain was placed in the posterior part of the incision. The total surgical time was 60 minutes. The patient was discharged home on the second postoperative day without complications after the drain was removed. The final pathological examination revealed CCAM.

Figure 2A. Surgical single incision. Figure 2B. Thoracoscopic instrumentation through the incision.
Discussion
Congenital cystic adenomatoid malformation (CCAM) is an abnormality of the lung with adenomatoid cyst proliferation. The etiology remains unknown. Hamartomatous change in the terminal bronchioles or aberrant embryogenesis at or before the seventh gestational week producing cystic distortion of the lung architecture is suspected [1].
The Stocker classification subdivides CCAM in three types according to the size of the cysts and other histologic criteria. The most frequent is Type 1: one or more cysts (2-10 cm diameter) with mucinogenic differentiation.
This anomaly has been rarely described in adults in association with other malformations like bronchial atresia or brochopulmoary sequestration. Bronchial atresia and CCAM usually involve the same lobe, usually unilateral [2] and, although it has been stated that congenital cysts of the lung are due to abnormal bronchial development, the exact embryological and physiopathological mechanism is uncertain. Congenital bronchial atresia is a rare congenital obliteration of a segmental or lobar bronchus resulting in a hyperinflation of the correspondent obstructed lung segment.
The differential diagnosis includes bronchopulmonary sequestration, bronchogenic cyst, neurenteric cysts, congenital lobar emphysema, and diaphragmatic hernia [2,3,4].
The prognosis of CCAM presenting in adulthood depends on its pathological features and the potential for malignant transformation like bronchioalveolar carcinoma [5] or blastoma [6]. Regardless of size, the mass should be removed when possible to prevent the development of secondary complications like recurrent infections and the development of malignancy.
CCAM or bronchial atresia can be treated by wedge or anatomic segmental resection but patients with large bronchogenic cysts and who present with recurrent pneumonia are more likely to require a segmentectomy or a lobectomy [7,8]. Thoracoscopic approach is the less invasive method and must be performed by experienced VATS surgeons. Recent articles have reported lobectomy as the treatment of choice, and VATS approach must be considered in these young patients [9,10].
The VATS approach to lobectomy is usually performed by using three to four incisions but the surgery can be performed by using only one. Since June 2010, when we performed the first reported single-port VATS lobectomy [11] we routinely use the uniportal approach in our unit for lobectomy. To date we have performed 280 major pulmonary resections with excellent postoperative results including complex and advanced cases [12,13, 14].
References
1. Lujan M, Bosque M, Mirapeix RM, Marco MT, Asensio O, Domingo C. Late-onset congenital cystic adenomatoid malformation of the lung: embryology, clinical symptomatology, diagnostic procedures, therapeutic approach and clinical follow-up. Respiration. 2002;69(2):148-54
2. Margi M, Kaddouri N, Abdelhak M, Barahioui M, Benhmamouch MN.Cystic adenomatoid malformations of the lung: a retrospective study of 12 cases.Rev Pneumol Clin. 2009;65(3):143-6
3. N. Orpen, R. Goodman, C. Bowker, and K. Lakhoo. Intralobar pulmonary sequestration with congenital cystic adematous malformation and rhabdomyomatous dysplasia. Pediatr Surg Int. 2003;19(8):610-1
4. Lecomte B, Hadden H, Coste K, Gallot D, Laurichesse H, Lemery D, Scheye T, Dechelotte P, Labbé A. Hyperechoic congenital lung lesions in a non-selected population: from prenatal detection till perinatal management. Prenat Diagn. 2009;29(13):1222-30.
5. West D, Nicholson AG, Colquhoun I, Pollock J. Bronchioloalveolar carcinoma in congenital cystic adenomatoid malformation of lung. Ann Thorac Surg. 2007;83(2):687-9.
6. Nasr A, Himidan S, Pastor AC, Taylor G, Kim PC. Is congenital cystic adenomatoid malformation a premalignant lesion for pleuropulmonary blastoma? J Pediatr Surg. 2010;45(6):1086-9.
7. Makhija Z, Moir CR, Allen MS, Cassivi SD, Deschamps C, Nichols FC 3rd, Wigle DA, Shen KR. Surgical management of congenital cystic lung malformations in older patients. Ann Thorac Surg. 2011;91(5):1568-73
8. Muller CO, Berrebi D, Kheniche A, Bonnard A. Is radical lobectomy required in congenital cystic adenomatoid malformation? J Pediatr Surg. 2012;47(4):642-5
9. Kamiyoshihara M, Otaki A, Nameki T, Kawashima O, Otani Y, Sakata K, Morishita Y. Congenital bronchial atresia treated with video-assisted thoracoscopic surgery; report of a case. Kyobu Geka. 2004; 57(7):591-3.
10. Cappeliez S, Lenoir S, Validire P, Gossot D. Totally endoscopic lobectomy and segmentectomy for congenital bronchial atresia.Eur J Cardiothorac Surg. 2009;36(1):222-4.
11. Gonzalez D, Paradela M, Garcia J, de la Torre M. Single-port video-assisted thoracoscopic lobectomy. Interact Cardiovasc Thorac Surg. 2011;12:514-515
12. Gonzalez-Rivas D, Fernandez R, De la Torre M, Martin-Ucar A. Thoracoscopic lobectomy through a single incisionMultimedia Manual of Cardio-Thoracic Surgery. MMCTS (2012) Vol. 2012 doi:10.1093/mmcts/mms007.
13. Gonzalez-Rivas D, Paradela M, Fieira E, Velasco C. Single-incision video-assisted thoracoscopic lobectomy: Initial results .J Thorac Cardiovasc Surg. 2012;143:745-7
14. Gonzalez-Rivas D, Paradela M, Fernandez R, Delgado M, Fieira E, Mendez L, Velasco C, De la Torre M Uniportal Video-Assisted Thoracoscopic Lobectomy: Two Years of Experience. Ann Thorac Surg 2013;95:426-432.
